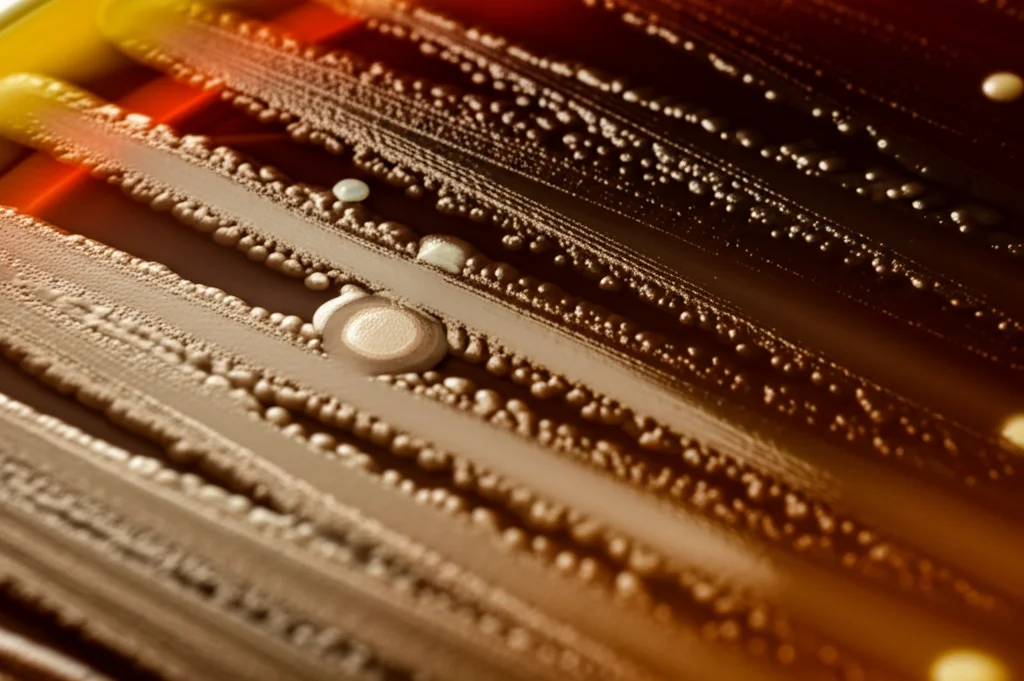
Immagine macrofotografica ad alta definizione di diverse colonie batteriche colorate e texturizzate su una piastra di Petri scura, illuminazione laterale controllata per enfatizzare i dettagli, obiettivo macro 100mm, messa a fuoco precisa su alcune colonie centrali.

Batteri Alchimisti: Svelando un Universo Nascosto di Molecole Naturali
Ciao a tutti! Oggi voglio portarvi con me in un viaggio affascinante, un’esplorazione nel cuore microscopico del nostro pianeta, alla scoperta di tesori chimici che non avremmo mai immaginato potessero esistere proprio lì, nei batteri. Parliamo di terpenoidi, una famiglia vastissima di prodotti naturali – pensate, oltre 100.000 composti conosciuti! Li troviamo ovunque: sono la base di molti farmaci (come il famoso antitumorale Taxol), erbicidi, aromi, profumi e persino biocarburanti.
Siamo abituati a pensare che piante, funghi e organismi marini siano i “maestri” nella produzione di queste molecole. E i batteri? Beh, fino a poco tempo fa, si pensava fossero attori secondari in questo campo. Meno del 2% dei terpenoidi conosciuti proveniva da loro, e per i diterpeni (la sottoclasse C20 a cui appartiene il Taxol), la percentuale scendeva addirittura sotto l’1%! Sembrava quasi un dogma scientifico.
Ma la scienza, si sa, ama mettere in discussione le certezze. E se vi dicessi che sotto la superficie si nascondeva un potenziale enorme e inesplorato?
La Mappa del Tesoro nel DNA Batterico
Tutto inizia con degli enzimi speciali, le terpene sintasi (TS). Immaginatele come minuscoli artigiani molecolari che prendono precursori semplici e li trasformano in complesse strutture cicliche, vere e proprie architetture chimiche. Questi enzimi sono ovunque in natura, ma la loro presenza nei genomi batterici era un indizio intrigante. Studi precedenti avevano già iniziato a scovare centinaia di potenziali geni TS nei batteri, suggerendo che forse avevamo sottovalutato le loro capacità.
Con l’esplosione delle librerie genomiche microbiche, la situazione è diventata ancora più chiara: una semplice ricerca nel database UniProt rivela migliaia di proteine batteriche potenzialmente correlate alle TS! Un numero impressionante che ci ha fatto chiedere: quanti di questi geni sono davvero attivi? E che tipo di molecole producono?
È qui che è iniziata la nostra avventura. Abbiamo deciso di andare a caccia, non con pala e piccone, ma con le tecniche del genome mining, della filogenetica e dell’analisi dei cluster genici biosintetici (BGC). Abbiamo selezionato una “squadra” di 334 terpene sintasi batteriche non ancora caratterizzate, provenienti da una vasta gamma di batteri: 8 phyla diversi, 17 classi e 83 generi. Una diversità incredibile, scelta apposta per avere una panoramica il più ampia possibile.
Una Fabbrica Molecolare in Provetta
Come testare tutti questi enzimi? Purificarli uno per uno sarebbe stato un lavoro immane. Abbiamo quindi optato per un approccio più smart: usare un “ospite” ben conosciuto, il batterio Escherichia coli, modificato geneticamente per produrre in abbondanza il substrato di partenza per i diterpeni, il geranilgeranil difosfato (GGPP). In pratica, abbiamo trasformato *E. coli* in una piccola fabbrica, inserendo in ciascuna “linea di produzione” uno dei nostri 334 geni TS candidati.
Abbiamo coltivato questi batteri ingegnerizzati e poi siamo andati a “vedere” cosa avevano prodotto. Con tecniche come la cromatografia su strato sottile (TLC) e la cromatografia liquida ad alte prestazioni (HPLC), abbiamo cercato tracce di nuove molecole. I risultati sono stati elettrizzanti: ben 125 dei 334 enzimi testati (il 37%!) hanno mostrato attività come diterpene sintasi (di-TS)! Un numero ben superiore alle aspettative, che quasi raddoppia il numero di di-TS batteriche conosciute fino a quel momento.
Alla Scoperta di Gioielli Chimici Inediti
Da questo primo screening, abbiamo selezionato 31 TS particolarmente promettenti (per diversità, potenziale biosintetico o alta produzione iniziale) per uno studio più approfondito. Abbiamo scalato la produzione e ci siamo messi al lavoro per isolare e identificare le molecole prodotte. Utilizzando tecniche sofisticate come la risonanza magnetica nucleare (NMR), la gascromatografia-spettrometria di massa (GC-MS) e una tecnica potentissima per determinare la configurazione assoluta chiamata dicroismo circolare vibrazionale (VCD), abbiamo svelato le strutture di 28 diterpeni.
E qui arriva il bello! Le scoperte si possono raggruppare in alcune categorie principali, anche se alcune molecole potrebbero appartenere a più di una:
- Scheletri Molecolari Mai Visti Prima: Abbiamo identificato tre strutture diterpeniche completamente nuove, mai osservate in natura!
- La Tetraisoquinene (1): Prodotta da un TS (TiqS) proveniente da un mixobatterio, Melittangium boletus. È la prima di-TS caratterizzata da questo gruppo di batteri, noti produttori di altre molecole ma non di diterpeni. Ha una complessa struttura tetraciclica 5/5/5/5 fusa, simile solo superficialmente alle crinipelline fungine, ma con connessioni diverse. Nessuno sapeva come venissero prodotte queste strutture!
- Il Salbirenol (2): Un alcol diterpenico triciclico 7/5/6, isolato da un ceppo di Streptomyces albireticuli. La sua struttura tridimensionale è stata definita con precisione grazie alla VCD.
- La Chitino-2,5(6),9(10)-triene (3): Una molecola biciclica 5/11 prodotta da Chitinophaga japonensis. A prima vista ricorda i dolabellatrieni, ma la posizione dei gruppi metilici sull’anello a 11 termini la rende unica, uno scheletro mai descritto prima.
- Molecole Note, Origine Inaspettata: Abbiamo trovato diterpeni con scheletri già conosciuti in piante, funghi o alghe, ma mai (a nostra conoscenza) nei batteri. E spesso, per queste molecole non si conosceva nemmeno l’enzima responsabile della loro sintesi!
- Il Peysonnosene (4): Identico allo scheletro dei peyssonnosidi, diterpeni glicosidici isolati dall’alga rossa marina Peyssonnelia. È stato prodotto da un batterio del phylum Chloroflexota, Anaerolineaceae sp., che guarda caso si trova spesso nei sedimenti marini. Un possibile legame tra batteri e alghe?
- Il Clavulara-1(15),17-diene (5): Uno scheletro triciclico 6/7/5, simile ai clavularani isolati dai coralli. Prodotto da Nocardia vulneris.
- Il Variediene (6): Un triciclo 5/5/9, prodotto da ben due TS batteriche molto diverse tra loro (da Actinomycetota e Bacteroidota), mentre prima era noto solo da enzimi fungini “chimerici”.
- I Verticilleni (7 e 8): Scheletri biciclici 6/12, correlati biosinteticamente ai taxani (come il Taxol). Trovati in due batteri diversi, mentre prima erano noti in piante, coralli e insetti.
- Il (-)-Sandaracopimaradiene (9): Prodotto da un enzima particolarmente interessante di Chitinophaga japonensis. Questo TS è risultato essere bifunzionale, capace cioè di compiere due passaggi catalitici diversi (attività di tipo II e poi di tipo I). È uno dei primissimi esempi di questo tipo scoperti nei batteri, aprendo nuove finestre sull’evoluzione di questi enzimi.

Variazioni sul Tema e Conferme
Oltre a queste scoperte eclatanti, abbiamo trovato molte altre molecole interessanti:
- Nuovi Isomeri Strutturali o Stereochimici: Abbiamo isolato varianti di diterpeni già noti, come diverse versioni delle venezuelaene (10, 11) o dell’odyverdiene B2 (12), prodotte da enzimi simili ma non identici. Abbiamo anche trovato nuovi dolabellatrieni (13, 14, 15), precursori di famiglie note, e identificato per la prima volta una di-TS da cianobatteri (che produce il composto 15). Addirittura, due enzimi con solo il 27% di identità (da Kibdelosporangium e Streptomyces) producono due diastereoisomeri (16 e 17) dello stesso scheletro triciclico 5/8/5!
- Produttori Diversi per Molecole Note: In alcuni casi, abbiamo trovato TS batteriche che producono diterpeni già conosciuti, ma queste TS provenivano da batteri diversi o avevano sequenze molto differenti da quelle note. Ad esempio, il benditerpetriene (19), noto nella biosintesi di alcuni antibiotici, è stato prodotto da TS di Nocardia e persino del patogeno Mycobacteroides abscessus. Abbiamo anche trovato i primi enzimi specifici per il prehydropyrene (20), un intermedio biosintetico. Il micromonocyclol (21), con il suo raro anello a 15 termini, è stato riscoperto da tre nuove TS. E così via per cembrene A (22), nepthenolo (23), isocembrene C (24), spiroviolene (25), ecc.
Curiosamente, una TS che inizialmente produceva solo il prodotto di eliminazione lineare β-springene (28), si è poi rivelata essere una sesterterpene sintasi, confermando che la nostra libreria contiene enzimi con diverse specificità di substrato.
La Prova del Nove: Dalla Fabbrica *E. coli* alla Provetta
Una domanda legittima era: siamo sicuri che queste molecole siano davvero prodotte dagli enzimi che abbiamo identificato, e non siano artefatti del sistema di espressione in *E. coli*? Per toglierci ogni dubbio, abbiamo purificato sei delle nostre TS più interessanti (TiqS, SalS, PeyS, OdVS, SalkS, SPhpS) e le abbiamo testate in vitro, in provetta, fornendo loro direttamente il substrato GGPP. Il risultato? Hanno prodotto esattamente le stesse molecole principali che avevamo isolato da *E. coli*! Una conferma importante che i nostri risultati riflettono l’attività genuina di questi enzimi batterici.

Un Universo Chimico da Esplorare
Cosa ci dice tutto questo? Che il “terpenoma” batterico, l’insieme dei terpenoidi codificati nei genomi batterici, è molto, molto più vasto e diversificato di quanto pensassimo. Abbiamo quasi raddoppiato il numero di di-TS batteriche caratterizzate con un solo studio! E siamo solo all’inizio: molti degli enzimi che non hanno prodotto diterpeni potrebbero essere attivi su precursori di lunghezza diversa (mono-, sesqui- o sesterterpeni), e stiamo già indagando.
Queste scoperte non sono solo “curiosità” accademiche. Aprono strade immense:
- Scoperta di Nuovi Prodotti Naturali: Molti di questi diterpeni potrebbero essere precursori di molecole più complesse con attività biologiche utili (farmaci, antibiotici, ecc.).
- Comprensione della Biosintesi e dell’Enzimologia: Studiare come questi enzimi riescono a creare strutture così complesse e specifiche ci aiuta a capire i meccanismi della catalisi enzimatica e l’evoluzione molecolare.
- Ruoli Ecologici: Perché i batteri producono queste molecole? Forse per comunicare tra loro o con altri organismi, per difendersi, per interagire con l’ambiente. Trovare molecole simili in organismi diversi (batteri, piante, funghi, coralli) potrebbe darci indizi sui loro ruoli ecologici.
- Biocatalisi: Questi enzimi potrebbero essere usati come “biocatalizzatori” per produrre idrocarburi complessi in modo sostenibile.
Abbiamo anche sollevato domande intriganti: alcuni terpenoidi trovati in organismi superiori come alghe o coralli potrebbero in realtà essere prodotti da batteri simbionti? Anche se la scoperta recente di TS negli stessi coralli suggerisce che siano in grado di produrli da soli, la possibilità di un contributo batterico rimane aperta.
Insomma, abbiamo appena scalfito la superficie di un universo chimico nascosto nel mondo dei batteri. È come aver trovato una nuova mappa del tesoro, piena di indicazioni per future esplorazioni. Chissà quali altre meraviglie molecolari ci aspettano! Il viaggio è appena iniziato.
Fonte: Springer
